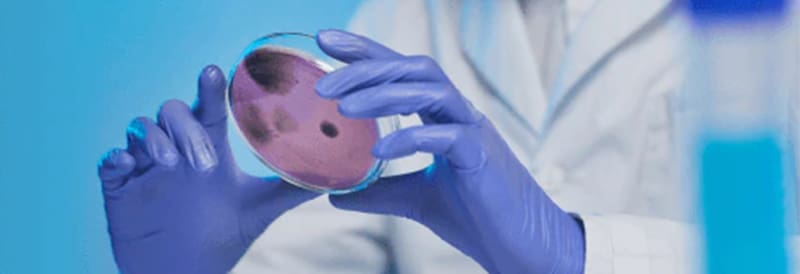
Clinical Microbiology Products

Histology, Cytology, and Anatomical Pathology Products
Your Source for Chemicals, Reagents, Solvents, and More
Count on the Fisher Scientific Channel for a range of chemicals and reagents, including histology-grade solvents designed specifically for medical laboratory professionals. You'll also find equipment and supplies to support each step of your workflow.